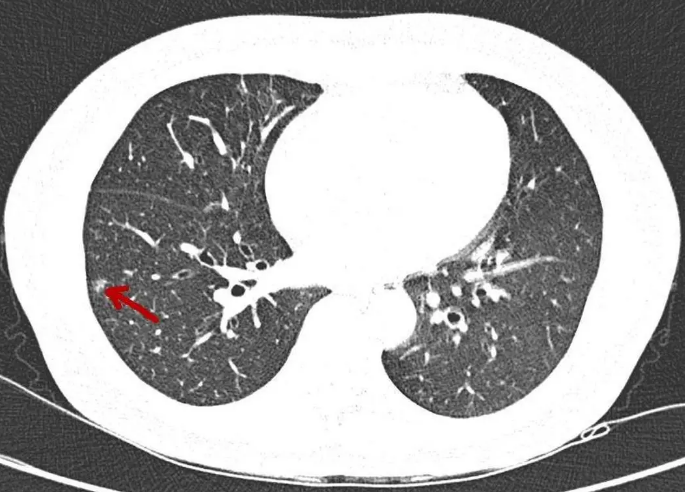
肺部结节

肺部结节是什么?
首先,如果在体检的时候看到报告单上写有肺部结节的结果,一定不要自己吓自己,要先了解肺部结节到底是一种什么东西。
这里有必要清楚关于肺部结节的概念,其实只要在体检的时候发现肺部上出现了跟正常肺部组织不一样的结节影,那么在报告单上都会出现“肺结节”,一般大于两厘米以上的肺部结节医生会称为“肿物”,而小于两厘米的则称为“肺结节”,其实有很多人在体检的时候都会发现肺部结节,但是有百分之九十五以上的都是良性的,特别是如果肺部结节的直径小于五毫米的都是良性的。
因此,一定不要在看到报告单上的肺部结节就想到了肺癌,而应该听从医生的专业建议,配合进行进一步的检查确诊。那么,有哪些原因会导致产生肺部结节呢?
什么原因会导致肺结节产生?
一,经常吸烟的人肺部容易遭受损伤,因此产生肺结节的可能性也比较大,很多有多年吸烟史的老烟民在在胸片的时候就会看到报告上写有肺结节。
二,有一些职业导致产生肺结节的概率也比较高,比如电焊工、在矿场工作的矿工,这些人由于长期吸入灰尘异物,肺部也更容易受到伤害,因此产生肺结节的概率也比较高。
三,如果是胸部曾经受过外伤的人,容易引起肺部的淤血,这种情况下也是会出现肺结节的。
四,患有肺部良性肿瘤的患者,比如硬化性血管瘤等,也容易在检查的时候发现肺结节。
有肺癌的患者,在早期也会出现肺结节,所以可以发现,有很多原因会导致肺结节的出现,并不是只有肺癌才会发现肺结节,而且肺结节也并不一定就会变成肺癌。